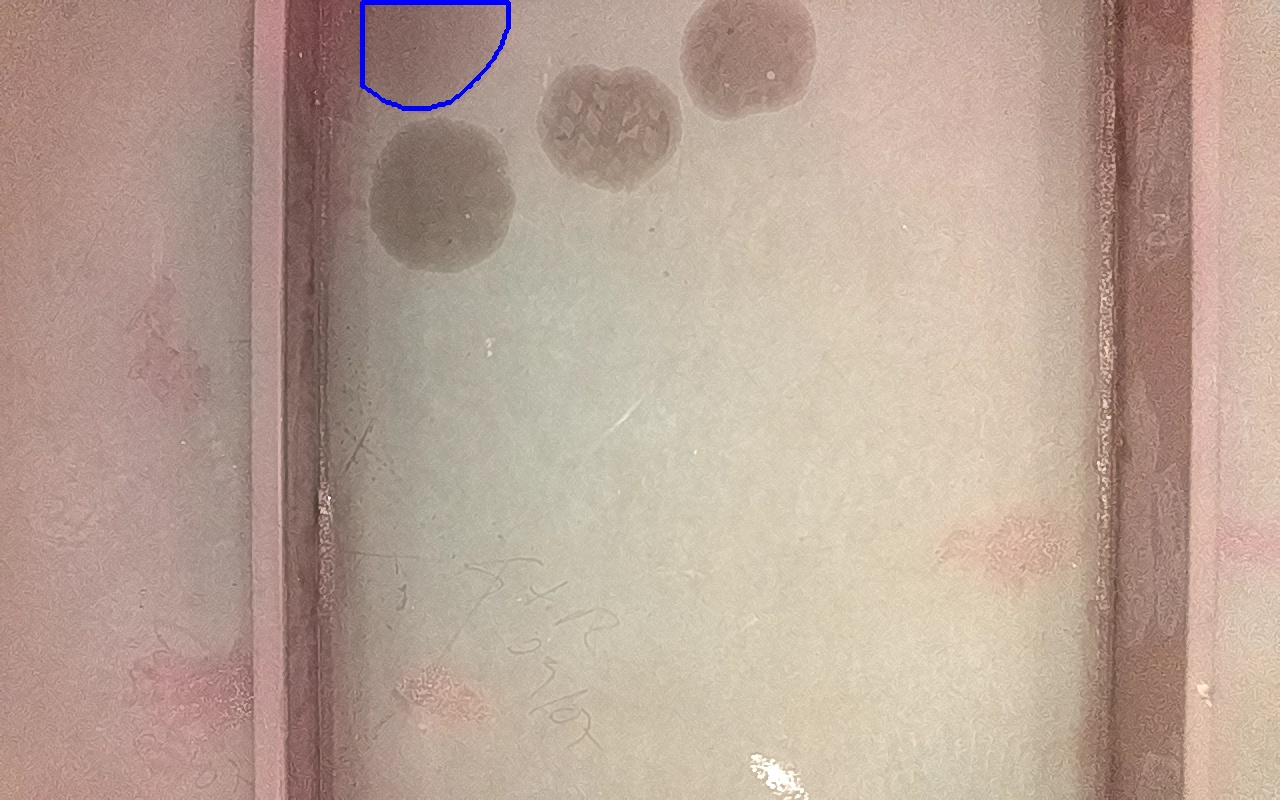

Proviene de:
IV-2
ID: 260752

Confianza: 58.46 %
13162 mm2
(x: 2.93, y: 0.01, z: 0.0)
Marcas de aceite o grasa. Suciedades o todo tipo de contaminantes solubles.
Incluído en discontinuidad final: 265603
IV-2
ID: 260765

Confianza: 33.87 %
14779 mm2
(x: 2.93, y: 0.02, z: 0.0)
Marcas de aceite o grasa. Suciedades o todo tipo de contaminantes solubles.
Incluído en discontinuidad final: 265603
IV-2
ID: 260891

Confianza: 69.89 %
8696 mm2
(x: 2.87, y: 0.03, z: 0.03)
Marcas de aceite o grasa. Suciedades o todo tipo de contaminantes solubles.
Incluído en discontinuidad final: 265603
IV-2
ID: 260900

Confianza: 76.5 %
8908 mm2
(x: 2.87, y: 0.03, z: 0.03)
Marcas de aceite o grasa. Suciedades o todo tipo de contaminantes solubles.
Incluído en discontinuidad final: 265603
IV-2
ID: 260912

Confianza: 52.83 %
7866 mm2
(x: 2.87, y: 0.02, z: 0.02)
Marcas de aceite o grasa. Suciedades o todo tipo de contaminantes solubles.
Incluído en discontinuidad final: 265603
Discontinuidad detectada
| Tipo |
IV-2
Marcas de aceite o grasa. Suciedades o todo tipo de contaminantes solubles. |
|---|---|
| Fecha | 26/06/2025 17:13 |
| Tamaño (mm) | 14779 mm2 |
| Tamaño (m) | 0.0148 m2 |
| Confianza | 76.5 % |
| Posición |
X: 2.91 Y: 0.03 Z: 0.01 |